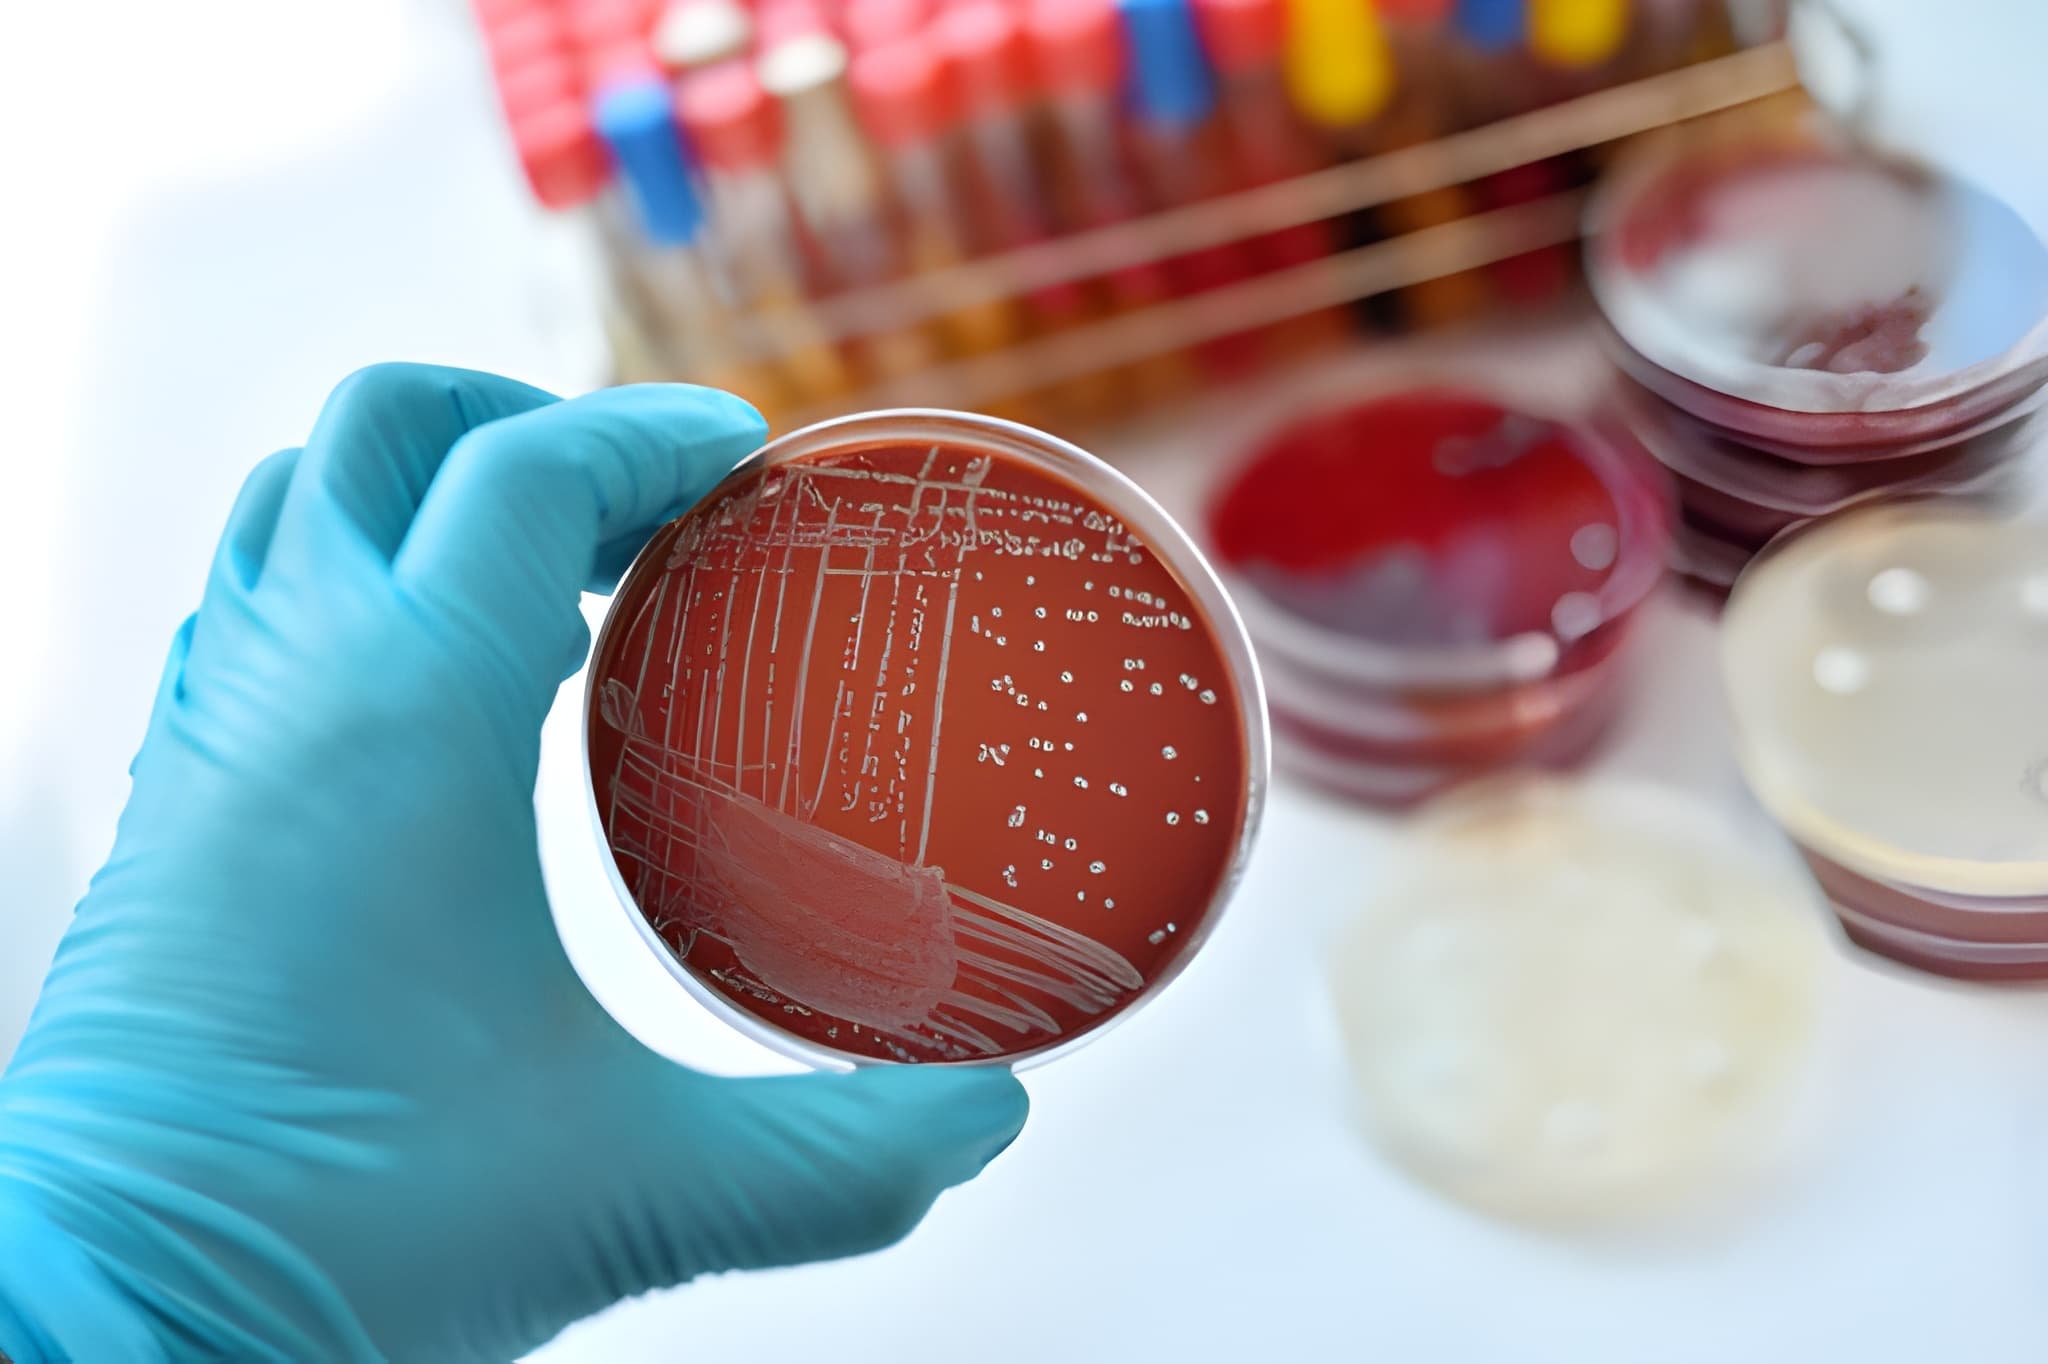
Bacteriología y Parasitología

Bienvenido(a) a Laboratorios Balderas
Somos un laboratorio comprometido con la salud y el bienestar de nuestros pacientes, drindándoles un servicio de calidad y resultados confiables.
Misión: Brindar a la población análisis clínicos confiables y de calidad para apoyar al diagnóstico oportuno de patologías clínicas, con base en la ética profesional y gran compromiso con la salud de cada uno de nuestros pacientes.
Visión: Ser un laboratorio que proporcione análisis clínicos de rutina y pruebas especiales llevadas a cabo en equipos con tecnología de punta al alcance de la población, convirtiéndonos en líderes del área de análisis clínico.
En LABORATORIO CLINICO BALDERAS, Nos complace servirle.

Blvd. Adolfo Ruiz
Cortines 1208
Fracc. Orpeza, Tabasco 2000
C.P.
86030, Villahermosa, Tab.
Lunes – Viernes: 6:30 A.M.
a 6:00 P.M.
Sábado: 6:30 A.M. a 4:00 P.M.
Domingo:
7:00 A.M. a 3:00 P.M.
Andrés García 249-B
Col.
Primero de Mayo
C.P. 86190, Villahermosa, Tab.
Lunes – Domingo:
7:00
A.M. a 2:30 P.M.
Tenochtitlán S/N
Col.
El Recreo
C.P. 86020, Villahermosa, Tab.
Lunes – Viernes: 6:30 A.M.
a 5:00 P.M.
Sábado: 6:30 A.M. a 4:00 P.M.
Domingo:
7:00 A.M. a 3:00 P.M.
